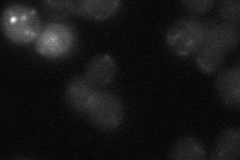
YDL210W

View description
Permease that serves as a gamma-aminobutyrate (GABA) transport protein involved in the utilization of GABA as a nitrogen source; catalyzes the transport of putrescine and delta-aminolevulinic acid (ALA); localized to the vacuolar membrane
Localization:
Intensity:
Fold change:
Significance:
-
C’ GFP library in SD

below threshold15.16 -
N' NOP1pr-GFP in SD

vacuole membrane63.5301 -
N' TEF2pr-mCherry in SD

vacuole105.347 -
N' NATIVEpr-GFP in SD
below threshold14.4451 -
N' TEF2pr-VC and Cyto-VN in SD

#N/A0 -
C’ GFP library in SD+DTT

cytosol15.120.99No -
C’ GFP library in SD+H2O2

cytosol15.91.04No -
C’ GFP library in Starvation Media

cytosol23.241.53No -
C’ GFP library on the background of Pup2-DaMP

below threshold -
C’ GFP library on the background of CCT mutant

below threshold13.8630.914049No
